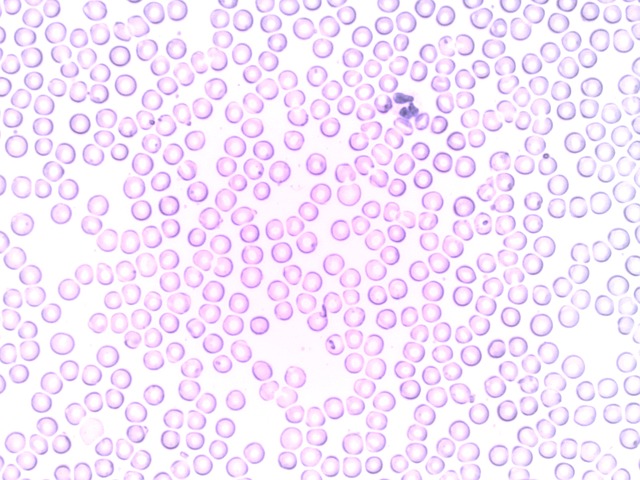

Pitää säilyttää miia.korpela@hus.fi 26.6.2025. Käytetään moodlen toimintojen testaamiseen ennen varsinaiselle koulutusalustalle laittamista.
- Teacher: Marja-Leena Järvi-Holopainen
- Teacher: Miia Korpela
- Teacher: Sari Lehtimäki
Pitää säilyttää miia.korpela@hus.fi 26.6.2025. Käytetään moodlen toimintojen testaamiseen ennen varsinaiselle koulutusalustalle laittamista.